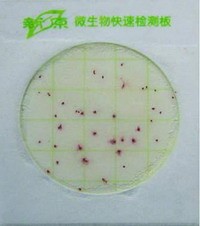
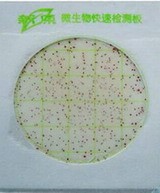

菌落總數(shù)檢測紙片(piàn)
- 產品簡介:型號:PZ-JC-WSW01規格:24片/包產品用途:各類食(shí)品及原料中菌落總數的快速檢測。適用對象:畜(chù)牧、食品藥品監督管理局、餐(cān)飲業(yè)、食堂產品特點:
次
1 適用範圍:
可用於各類食品及(jí)原料中菌落總數的測定。也(yě)可用於與食品接觸的容器、操作台和其他設備(bèi)表麵的(de)衛生檢測。
2 方法原理:
將營養培(péi)養基、凝膠和氯化(huà)三苯基四氮唑(TTC)顯色劑等加載在試紙片,經加樣、培養後,細菌菌落在測試片(piàn)上顯現出紅色菌斑,通過計數報告結果。
3 操作方法
(1)樣品處理:無菌稱(chēng)取樣品25g(或25mL)放(fàng)入含有225mL無菌生理鹽水的采樣(yàng)瓶或均質杯內,經充(chōng)分振搖(均質)做成1:10的稀(xī)釋液。用1mL滅菌吸管吸取1:10稀釋液1mL,注入含有9mL滅菌生理鹽水的試管內,用1mL滅菌吸管反複吸吹製成1:100的稀釋液。以此類推,做出1:1000等稀(xī)釋度的(de)稀釋液,每個稀釋度更換一支滅菌吸管。
(2)接種:一般食(shí)品選2~3個稀釋度進行檢測,含菌量少的液體樣品(pǐn)(如食用純水和礦泉水等)可(kě)直接用原液檢測。將測試片放在水平台麵上,揭開上麵的透明薄膜(mó),用(yòng)滅菌吸管吸取樣品原液或稀釋液1mL,均勻加到中央的紙(zhǐ)片(piàn)上,輕輕將上蓋膜放下,靜置5 min使培養基凝固,非常(cháng)後用手輕(qīng)輕地壓一下。每個稀釋(shì)度接種兩片。
(3)培養:將測試片疊在一起放回原自封袋中,透明麵朝上水平置於(yú)恒溫培養箱內,堆疊片數(shù)不超過(guò)12片。培養溫(wēn)度為(wéi)36℃±1℃,培養15~24h。
4 結果(guǒ)判斷與計數:
(1)細菌在紙(zhǐ)片上生長後會顯示紅色斑點,選擇菌落數適中(10個~100個)的紙片(piàn)進行計數,乘(chéng)以稀釋倍數後即為每克(或毫升)樣品中所(suǒ)含的細(xì)菌菌落總數。菌落數在100以(yǐ)內時,按實有數報(bào)告。大於100時,用二(èr)位(wèi)有效數字,二位有效(xiào)數字後麵的數(shù)字,以四舍五入方法計算,並以10的指數來表示。
(2)計(jì)數原則與報告方式
①通常選擇菌落(luò)在(zài)10個(gè)~100個之間的紙片進行計數,乘以稀釋倍數報告之(見下表中例次1)。國(guó)家標準菌(jun1)落總數報告方式術語為cfu/g或mL,cfu的含義為菌落形成單位。
②若有兩個稀釋度的菌落數(shù)在10個~100個之內,兩者的比值小於2,則取其(qí)平均(jun1)數,若大於2,則采用稀釋度小者(zhě)報告(見下表中(zhōng)例次2和例次3)。
③若三個稀釋度的菌落數(shù)都有在(zài)10個~100個之內時,應選擇(zé)二個低數值的平均數(見下表中例次4)
④若(ruò)三個稀釋度的菌落數均小於10個或大於100個時,應重新試用更低或更高的稀釋度進行菌落計數(shù);或采用均小於數量標準的非常小值,或采用均大於數量標準的(de)非常大值(見下表中例次5和例次6)。
例次 | 稀釋度 | 兩稀釋 度之比 | 選定計數 稀釋度 | 報(bào)告方式(個/g或 個/mL) |
10-1 | 10-2 | 10-3 |
1 2 3 4 5 6 | 158 208 265 98 8 295 | 76 68 82 50 5 174 | 5 12 50 15 1 106 | — 1.8 6.1 — — — | 10-2 10-2、10-3 10-2 10-1、10-2 10-1 10-3 | 7.6×103 9.4×103 8.2×103 3.0×103 8.0×10 1.1×105 |
5 表麵取樣方法:
加1mL滅菌生理鹽水在測試片上(shàng),靜置至少1h使培養基凝固;提起(qǐ)上層膜,使中央濾紙部分貼(tiē)到待測(cè)物表麵,用手在外側輕壓;然後將上蓋膜合上,置培養箱內培養。
6 注意事項:
使用過的紙片上帶有活菌,需(xū)及時按(àn)照生物安(ān)全廢棄物(wù)處理原則進行處理。


菌落數少時的情況菌落數多時(shí)的情況

脫氫乙酸速測盒
脫氫乙酸速測盒 水中餘氯速測盒(高(gāo)靈敏度)
水中餘氯速測盒(高(gāo)靈敏度) 水中尿素速測盒
水中尿素速測盒 山梨酸鉀速測盒(hé)
山梨酸鉀速測盒(hé) 揮發性鹽基氮速測(cè)盒
揮發性鹽基氮速測(cè)盒 餐具洗滌劑速測盒
餐具洗滌劑速測盒

